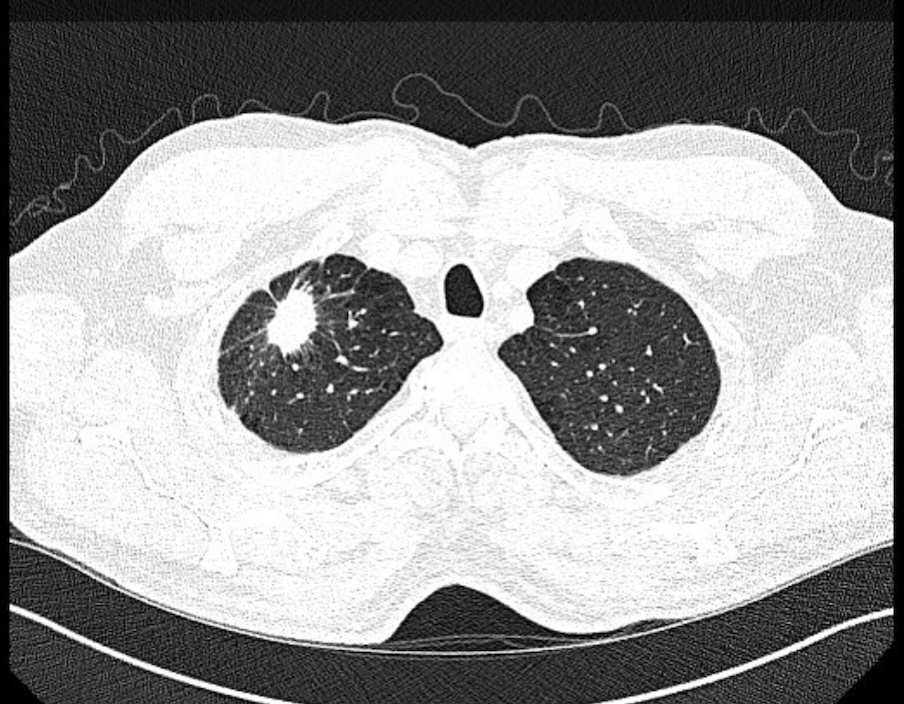
GS_Bronch tweet media

Tejaswi Nadig
130 posts


Tejaswi Nadig
@TejasNadig
Bangalore➡️ Atlantic City ➡️ Charleston.IP fellow at MSKCC #Thoraciconcology #Cricketfan, #RCBforlife. Tweets are my own and not medical advice.




📣 Register now for our upcoming @atscommunity webinar on Dec 2 at 4pm EST: “Components Necessary for High-Quality Lung Cancer Screening” featuring @JulieBartaMD, @LungDocDoug, and Peter Mazzone, and moderated by @RogerKimMD and Stella Ogake: thoracic.zoom.us/webinar/regist…

📣 Register now for our upcoming @atscommunity webinar on Dec 2 at 4pm EST: “Components Necessary for High-Quality Lung Cancer Screening” featuring @JulieBartaMD, @LungDocDoug, and Peter Mazzone, and moderated by @RogerKimMD and Stella Ogake: thoracic.zoom.us/webinar/regist…





Register now for our webinar on 9/11/25 at 12pm EST featuring presentations from our #ATS2025 @atstoa Abstract Award Winners! Link to register: thoracic.zoom.us/meeting/regist…









I’m excited to host this @atstoa webinar on Subsolid Pulmonary Nodule Evaluation and Management with @Lydia_SoYeonKim. It will feature experts #AndyHaas, @GavittWoodard, and #MarkHammer. Register here: thoracic.zoom.us/meeting/regist…


Our @atstoa is hosting a webinar on April 1 at 5pm ET on Exploring the Natural History, Clinical Outcomes, and Management of Subsolid Nodules. A multidisciplinary panel discussion on evaluation and management of subsolid pulmonary nodules. Register here: shorturl.at/SyLTH